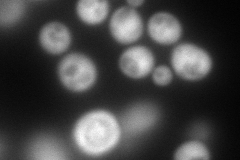
YJL217W
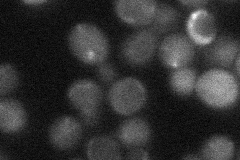
YJL217W
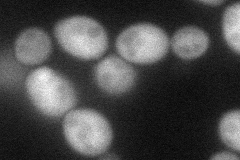
YJL217W
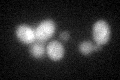
YJL217W

View description
Cytoplasmic protein involved in the regulation of enolase (ENO1); mRNA expression is induced by calcium shortage, copper deficiency (via Mac1p) and the presence of galactose (via Gal4p); mRNA expression is also regulated by the cell cycle
Localization:
Intensity:
Fold change:
Significance:
-
C’ GFP library in SD

cytosol21.76 -
N' NOP1pr-GFP in SD
cytosol295.942 -
N' TEF2pr-mCherry in SD

cytosol12.7136 -
N' NATIVEpr-GFP in SD
below threshold21.5038 -
N' TEF2pr-VC and Cyto-VN in SD
cytosol65.5536 -
C’ GFP library in SD+DTT
cytosol20.270.93No -
C’ GFP library in SD+H2O2

cytosol20.160.92No -
C’ GFP library in Starvation Media

cytosol15.530.71No -
C’ GFP library on the background of Pup2-DaMP

cytosol -
C’ GFP library on the background of CCT mutant

cytosol23.33551.07175No
